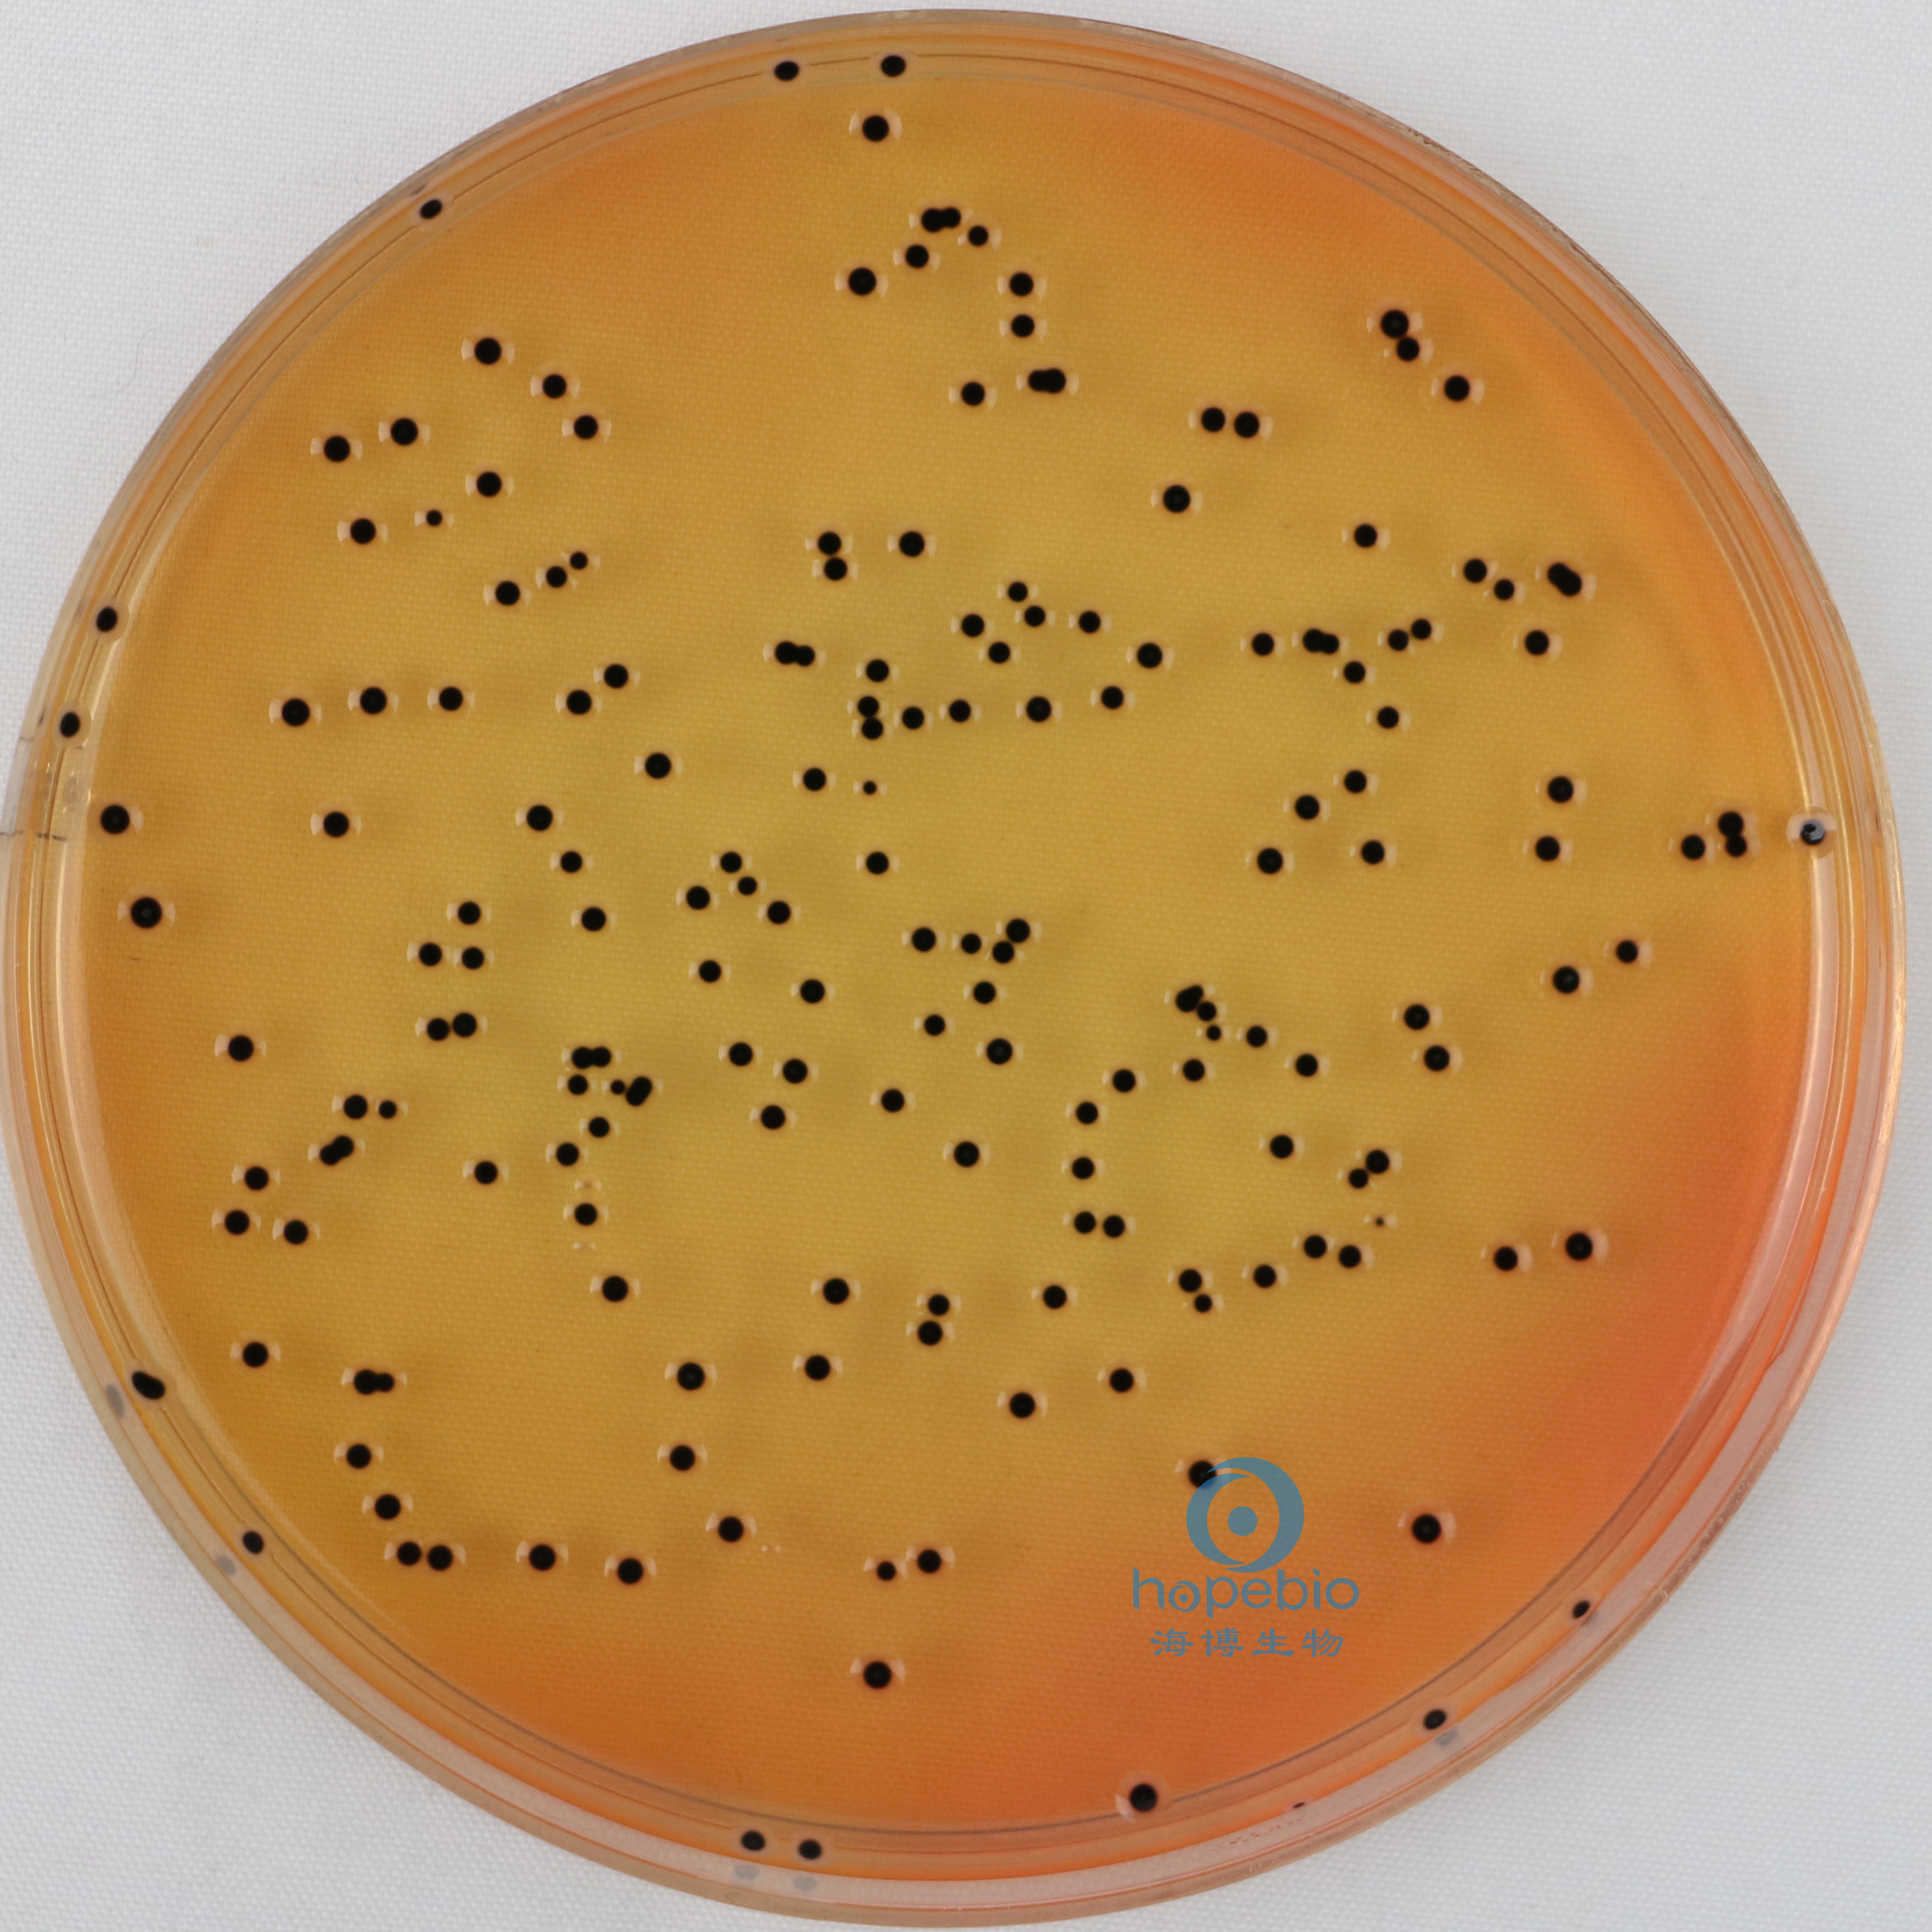
产品细节图片2
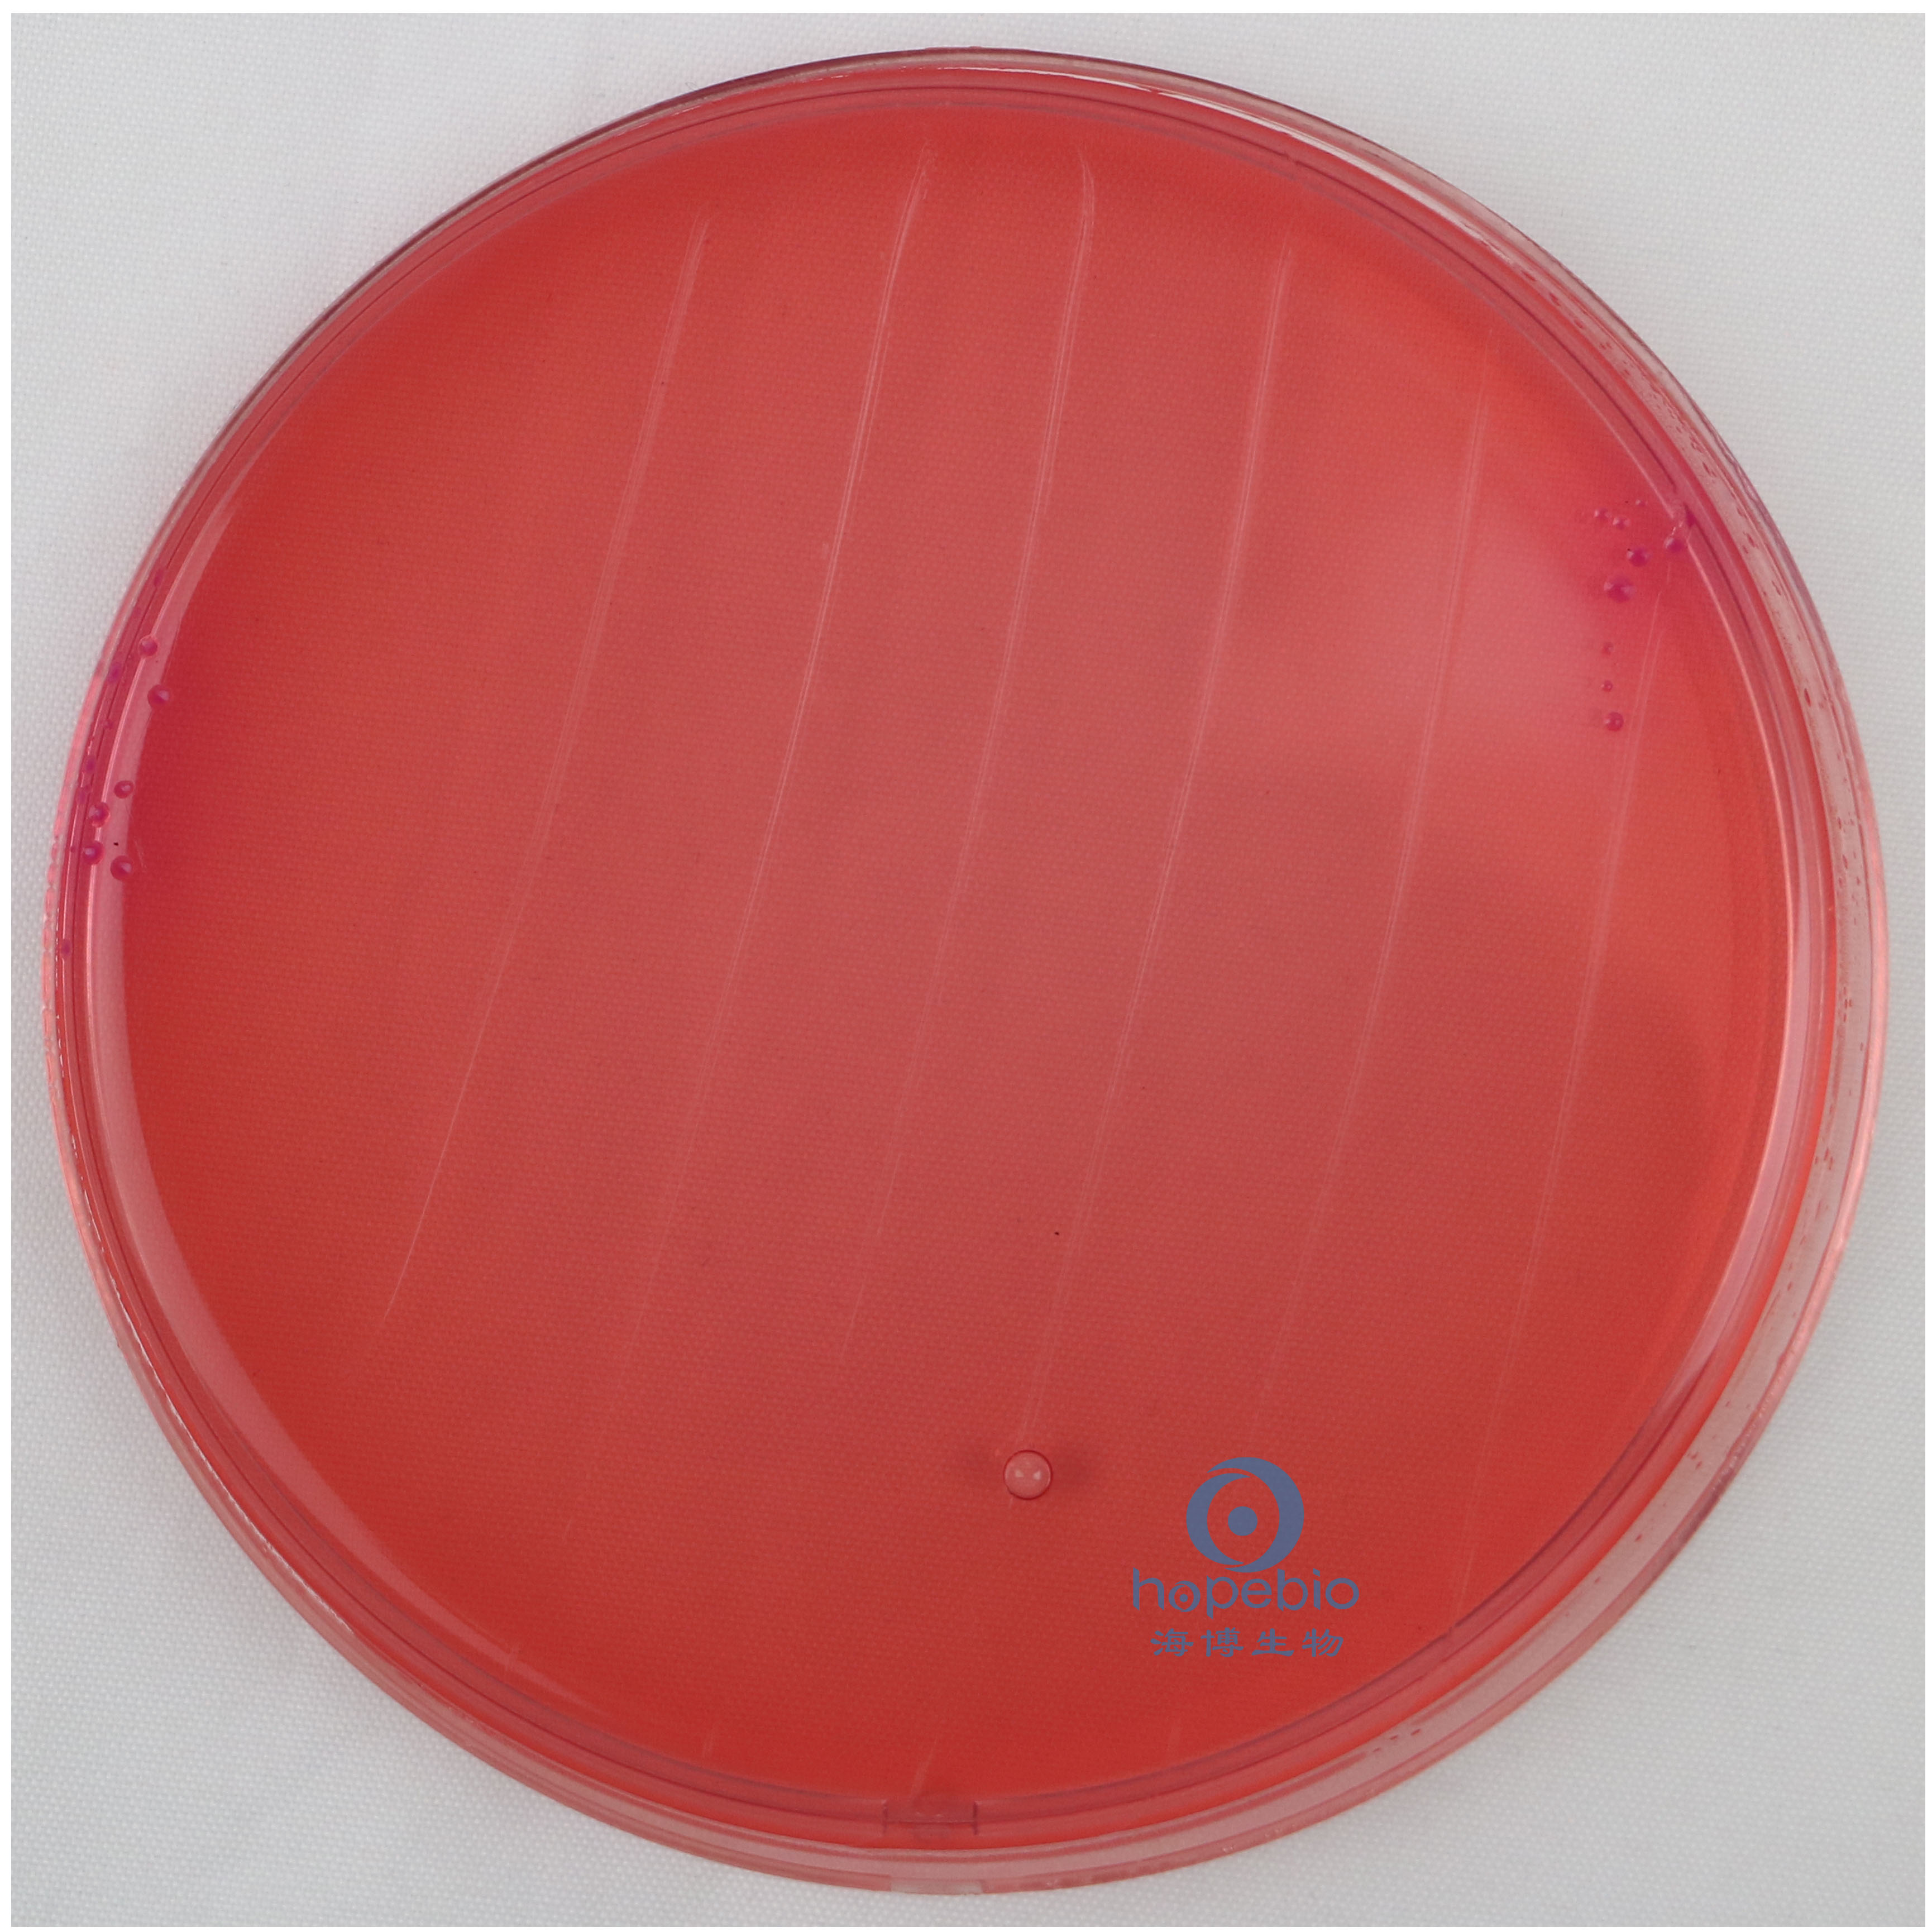
产品细节图片4
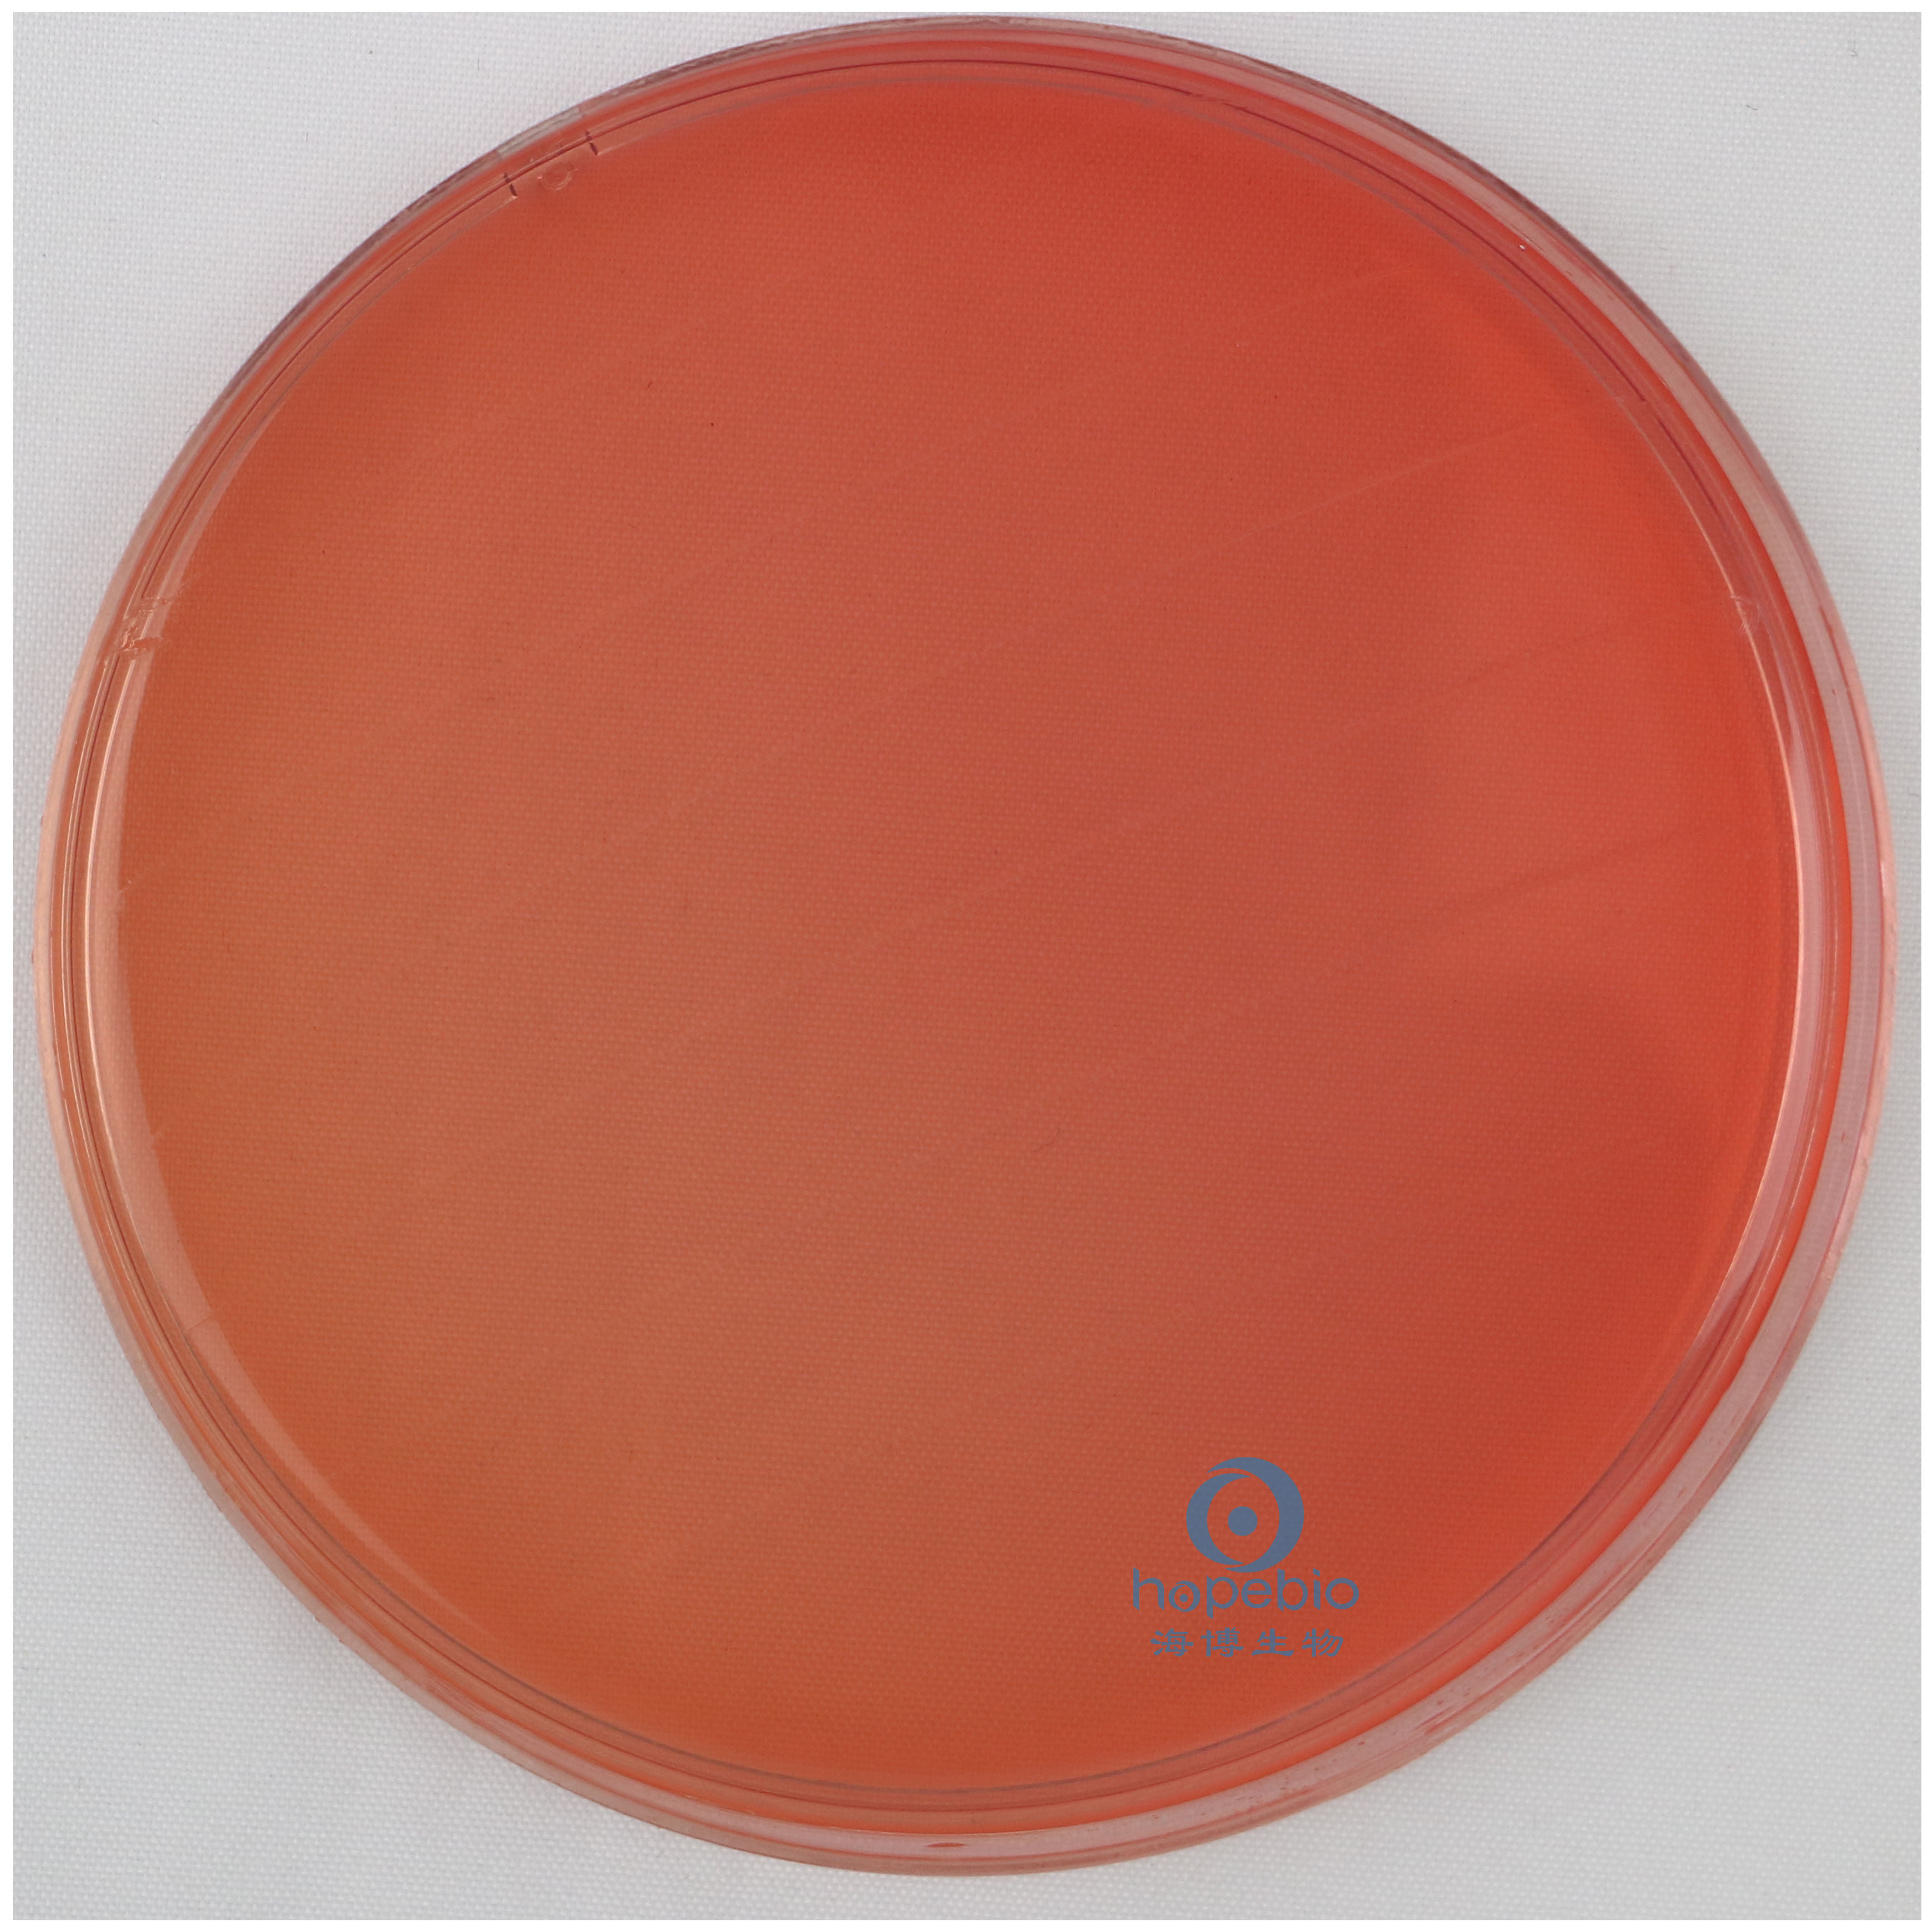
产品细节图片5

万千商家帮你免费找货
0 人在求购买到急需产品
- 详细信息
- 文献和实验
- 技术资料
- 保质期:
3年
- 供应商:
青岛海博生物
- 规格:
250g
1、产品用途:用于沙门氏菌,志贺氏菌的选择性分离培养
2、产品用法:称取本品 63.53g,加热煮沸溶解于 1000ml 蒸馏水中,冷至 60℃左右时,倾入无菌平皿,备用。
SS琼脂微生物质控结果:
沙门、志贺菌属琼脂培养基(SS)微生物灵敏度试验:
按标签用法制备培养基,接种以下质控菌株,放置30-35℃需氧培养18-24小时。
注:回收率计算时,用TSA琼脂做对照培养基。
2、产品用法:称取本品 63.53g,加热煮沸溶解于 1000ml 蒸馏水中,冷至 60℃左右时,倾入无菌平皿,备用。
SS琼脂微生物质控结果:
![]() |
![]() |
||
| 肠炎沙门氏菌 黑色中心菌落 |
鼠伤寒沙门氏菌 黑色中心菌落 |
![]() |
![]() |
||
| 福氏志贺氏菌 无色菌落,无黑心 |
大肠埃希氏菌 桃红色菌落 |
![]() |
| 金黄色葡萄球菌 |
沙门、志贺菌属琼脂培养基(SS)微生物灵敏度试验:
按标签用法制备培养基,接种以下质控菌株,放置30-35℃需氧培养18-24小时。
注:回收率计算时,用TSA琼脂做对照培养基。
风险提示:丁香通仅作为第三方平台,为商家信息发布提供平台空间。用户咨询产品时请注意保护个人信息及财产安全,合理判断,谨慎选购商品,商家和用户对交易行为负责。对于医疗器械类产品,请先查证核实企业经营资质和医疗器械产品注册证情况。
文献和实验相关实验
沙门菌显色培养基CHROMagar与普通培养基SS、HE的比对实验
中的优势特做如下比对试验。 1 材料和方法 1.1 材料 1.1.1 样本来源 选择2008年7~9月(东北腹泻流行季节)由吉林大学临床二院、吉林市医院肠道门诊送检的符合监测病例标准的腹泻病人的粪便或肛拭标本共1000份。 1.1.2 培养基 亚硒酸盐增菌液(SF)、沙门-志贺菌琼脂(SS、HE)和肠道综合双糖管及其肠杆菌科鉴定编码等培养基均购置北京陆桥生物技术公司;肠道菌生化鉴定卡API20E购置法国梅里埃公司;沙门菌显色培养基CAS产自法国
SS琼脂的干燥培养基。
成分 1 基础培养基 肉浸液 1000mL 蛋白胨 15g 氯化钠 5g 琼脂 25~30g pH7.5 2 50%葡萄糖水溶液。 3 50%卵黄盐水悬液。 制法 制备基础培养基,分装每瓶100mL。121℃高压灭菌15min。临用时加热溶化琼脂,冷至50℃,每瓶内加入50%葡萄糖水溶液2mL和50%卵黄盐水悬液
技术资料暂无技术资料 索取技术资料
沙门、志贺菌属琼脂培养基(SS)
¥170